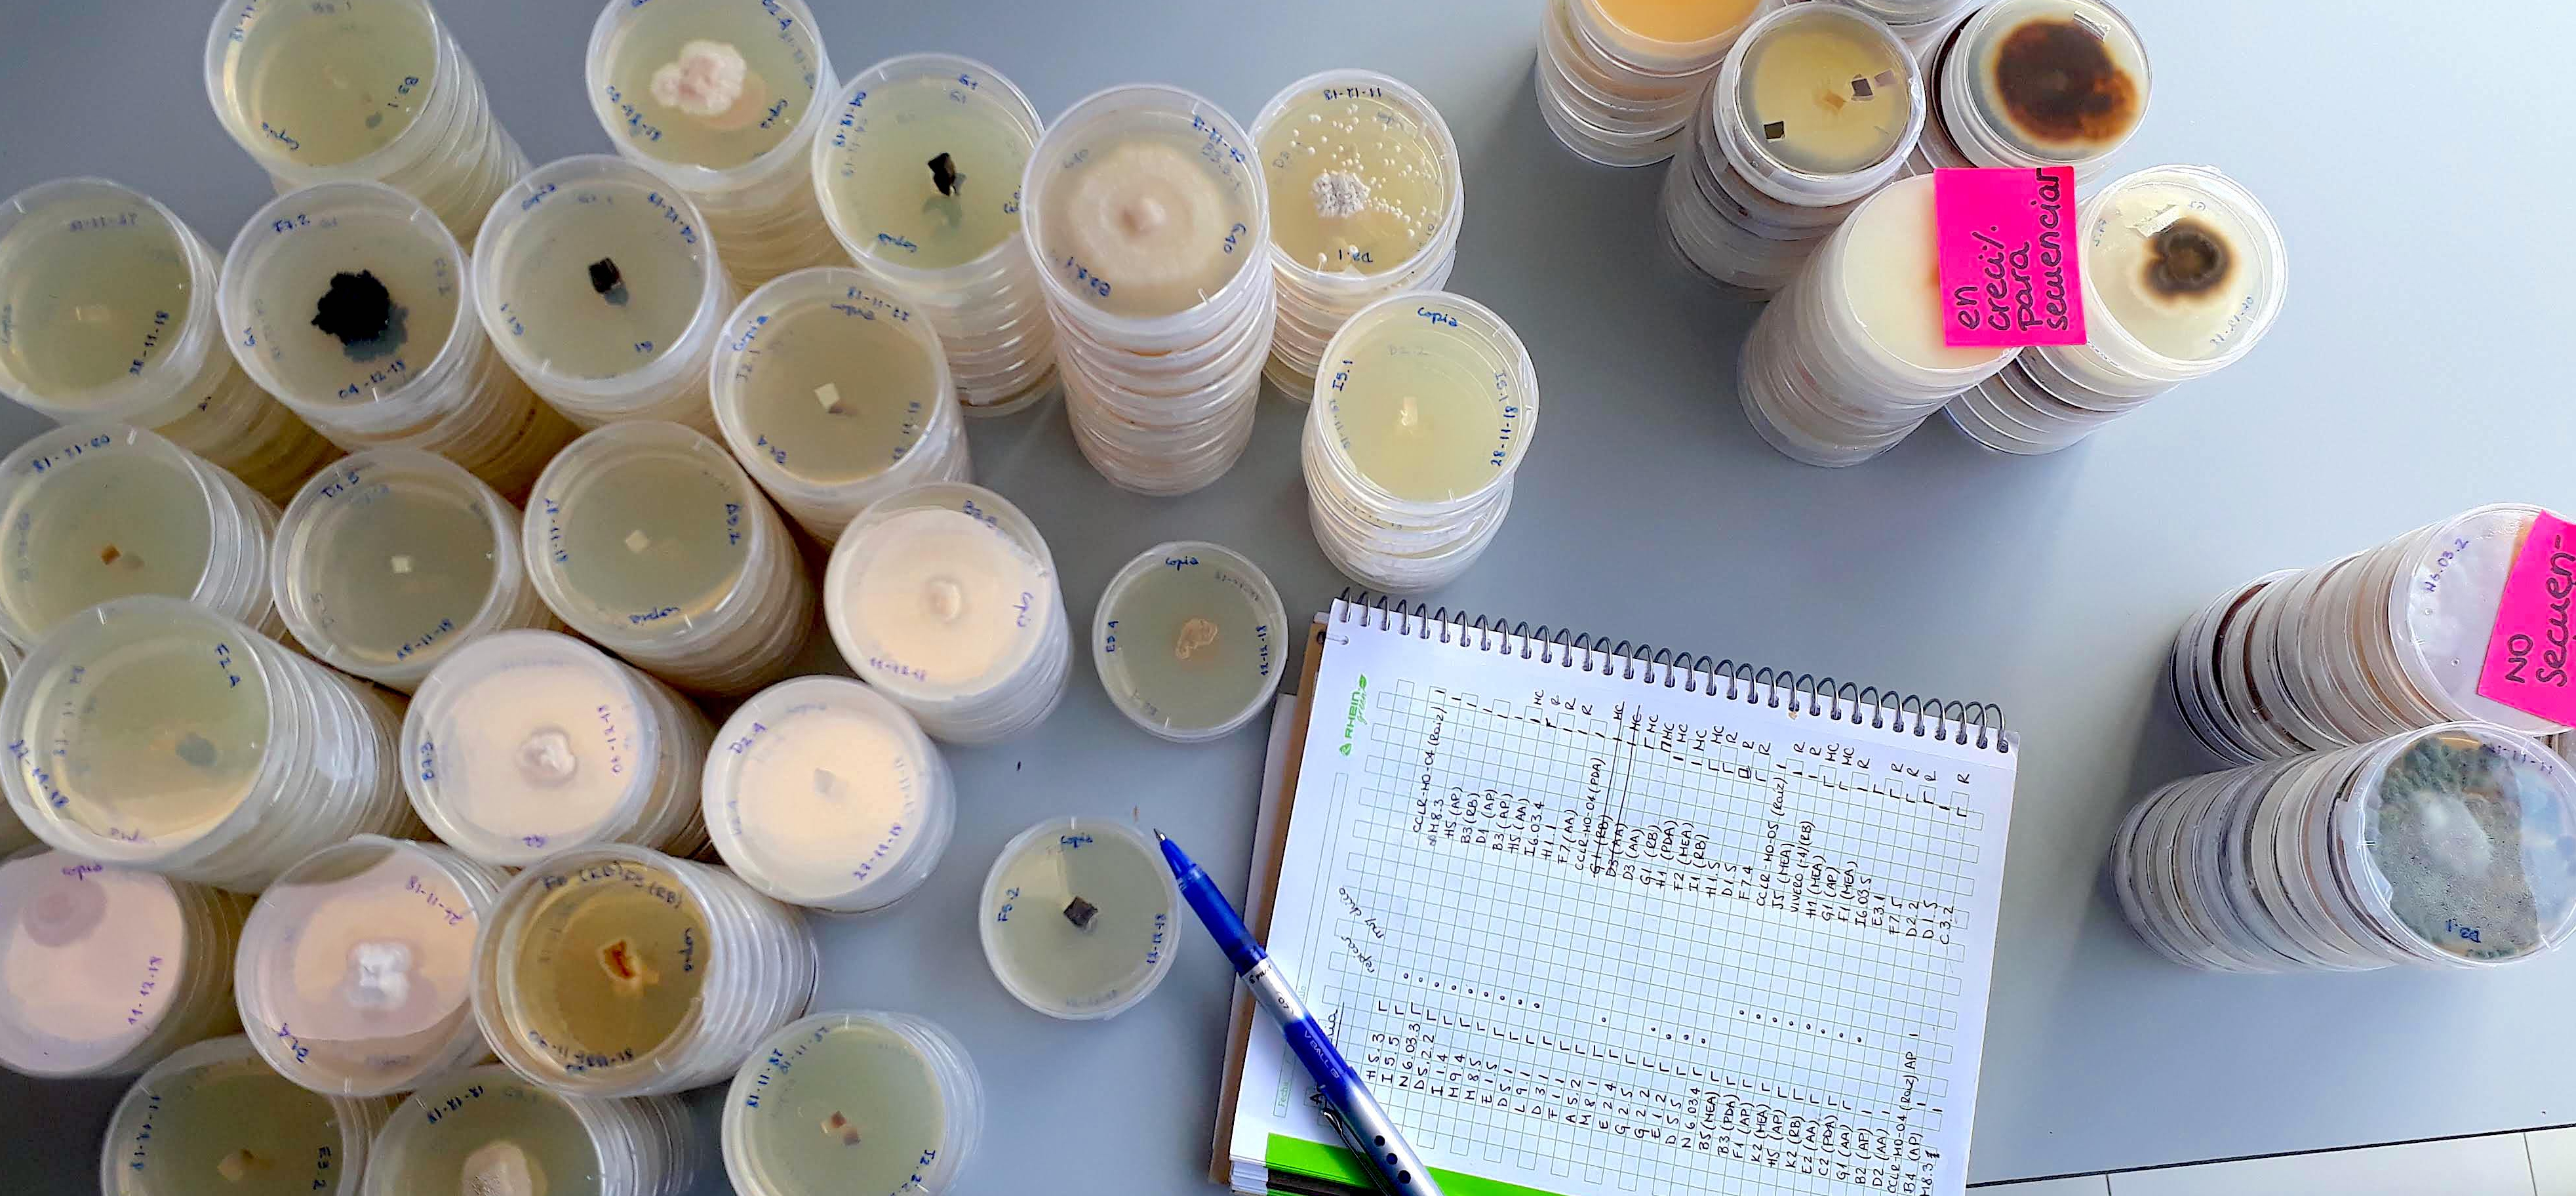

There is so much to learn and understand that I am always in awe. I try to fill that curiosity with my work and studies, but I also share it by teaching and communicating science to the general public.
There is so much to learn and understand that I am always in awe. I try to fill that curiosity with my work and studies, but I also share it by teaching and communicating science to the general public.